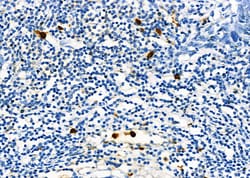
Invitrogen SIN3B Polyclonal Antibody 100 &mu;L; Unconjugated:Antibodies,

missing translation for 'onlineSavingsMsg'
Learn More
Learn More
Invitrogen™ SIN3B Polyclonal Antibody


Rabbit Polyclonal Antibody
Brand: Invitrogen™ PA599718
This item is not returnable.
View return policy
Description
Antibody detects endogenous levels of total Sin3B.
Acts as a transcriptional repressor. Interacts with MXI1 to repress MYC responsive genes and antagonize MYC oncogenic activities. Interacts with MAD-MAX heterodimers by binding to MAD. The heterodimer then represses transcription by tethering SIN3B to DNA. Also forms a complex with FOXK1 which represses transcription.
Specifications
| SIN3B | |
| Polyclonal | |
| Unconjugated | |
| SIN3B | |
| 2810430C10Rik; Histone deacetylase complex subunit Sin3b; KIAA0700; Paired amphipathic helix protein Sin3b; SIN3 homolog B, transcription regulator; SIN3 homolog B, transcriptional regulator; SIN3 transcription regulator family member B; SIN3 transcription regulator homolog B; SIN3B; Transcriptional corepressor Sin3b; transcriptional regulator, SIN3 yeast homolog B; transcriptional regulator, SIN3B; transcriptional regulator, SIN3B (yeast) | |
| Rabbit | |
| Affinity chromatography | |
| RUO | |
| 20467, 23309, 683381 | |
| -20°C | |
| Liquid |
| Immunohistochemistry (Paraffin), Western Blot, Immunocytochemistry | |
| 1 mg/mL | |
| PBS with 50% glycerol and 0.02% sodium azide; pH 7.4 | |
| O75182, Q62141 | |
| SIN3B | |
| A synthesized peptide derived from human SIN3B(Accession O75182), corresponding to amino acid residues E230-A280. | |
| 100 μL | |
| Primary | |
| Human, Mouse, Rat | |
| Antibody | |
| IgG |
Product Content Correction
Your input is important to us. Please complete this form to provide feedback related to the content on this product.
Product Title
Spot an opportunity for improvement?Share a Content Correction